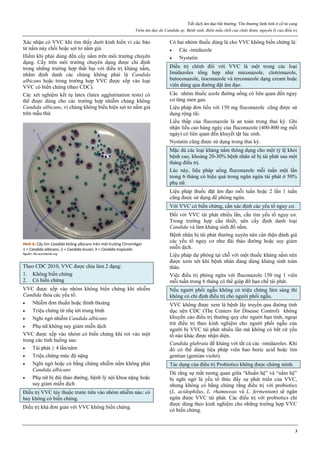
Tiết dịch âm đạo bất thường. Tổn thương lành tính ở cổ tử cung
Viêm âm đạo do Candida sp. Bệnh sinh, điểm mấu chốt của chẩn đoán, nguyên lý của điều trị
3
Xác nhận có VVC khi tìm thấy dưới kính hiển vi các bào
tử nấm nảy chồi hoặc sợi tơ nấm giả.
Hiếm khi phải dùng đến cấy nấm trên môi trường chuyên
dụng. Cấy trên môi trường chuyên dụng được chỉ định
trong những trường hợp thất bại với điều trị kháng nấm,
nhằm định danh các chủng không phải là Candida
albicans hoặc trong trường hợp VVC được xếp vào loại
VVC có biến chứng (theo CDC).
Các xét nghiệm kết tụ latex (latex agglutination tests) có
thể được dùng cho các trường hợp nhiễm chủng không
Candida albicans, vì chúng không biểu hiện sợi tơ nấm giả
trên mẫu thử.
Hình 6: Cấy tìm Candida không albicans trên môi trường ChromAgar
1 = Candida albicans; 2 = Candida krusei; 3 = Candida tropicalis.
Nguồn: life-worldwide.org
Theo CDC 2010, VVC được chia làm 2 dạng:
1. Không biến chứng
2. Có biến chứng
VVC được xếp vào nhóm không biến chứng khi nhiễm
Candida thỏa các yếu tố:
 Nhiễm đơn thuần hoặc thỉnh thoảng
 Triệu chứng từ nhẹ tới trung bình
 Nghi ngờ nhiễm Candida albicans
 Phụ nữ không suy giảm miễn dịch
VVC được xếp vào nhóm có biến chứng khi rơi vào một
trong các tình huống sau:
 Tái phát ≥ 4 lần/năm
 Triệu chứng mức độ nặng
 Nghi ngờ hoặc có bằng chứng nhiễm nấm không phải
Candida albicans
 Phụ nữ bị đái tháo đường, bệnh lý nội khoa nặng hoặc
suy giảm miễn dịch
Điều trị VVC tùy thuộc trước tiên vào nhóm nhiễm nào: có
hay không có biến chứng.
Điều trị khá đơn giản với VVC không biến chứng.
Có hai nhóm thuốc dùng là cho VVC không biến chứng là:
 Các -imidazole
 Nystatin
Điều trị chính đối với VVC là một trong các loại
Imidazoles tổng hợp như miconazole, clotrimazole,
butoconazole, tioconazole và terconazole dạng cream hoặc
viên dùng qua đường đặt âm đạo.
Các nhóm thuốc azole đường uống có liên quan đến nguy
cơ tăng men gan.
Liệu pháp đơn liều với 150 mg fluconazole cũng được sử
dụng rộng rãi.
Liều thấp của fluconazole là an toàn trong thai kỳ. Ghi
nhận liều cao hàng ngày của fluconazole (400-800 mg mỗi
ngày) có liên quan đến khuyết tật lúc sinh.
Nystatin cũng được sử dụng trong thai kỳ.
Mặc dù các loại kháng nấm thông dụng cho một tỷ lệ khỏi
bệnh cao, khoảng 20-30% bệnh nhân sẽ bị tái phát sau một
tháng điều trị.
Lúc này, liệu pháp uống fluconazole mỗi tuần một lần
trong 6 tháng có hiệu quả trong ngăn ngừa tái phát ở 50%
phụ nữ.
Liệu pháp thuốc đặt âm đạo mỗi tuần hoặc 2 lần 1 tuần
cũng được sử dụng để phòng ngừa.
Với VVC có biến chứng, cần xác định các yếu tố nguy cơ.
Đối với VVC tái phát nhiều lần, cần tìm yếu tố nguy cơ.
Trong trường hợp cần thiết, nên cấy định danh loại
Candida và làm kháng sinh đồ nấm.
Bệnh nhân bị tái phát thường xuyên nên cẩn thận đánh giá
các yếu tố nguy cơ như đái tháo đường hoặc suy giảm
miễn dịch.
Liệu pháp dự phòng tại chỗ với một thuốc kháng nấm nên
được xem xét khi bệnh nhân đang dùng kháng sinh toàn
thân.
Việc điều trị phòng ngừa với fluconazole 150 mg 1 viên
mỗi tuần trong 6 tháng có thể giúp đỡ hạn chế tái phát.
Nếu người phối ngẫu không có triệu chứng lâm sàng thì
không có chỉ định điều trị cho người phối ngẫu.
VVC không được xem là bệnh lây truyền qua đường tình
dục nên CDC (The Centers for Disease Control) không
khuyến cáo điều trị thường quy cho người bạn tình, ngoại
trừ điều trị theo kinh nghiệm cho người phối ngẫu của
người bị VVC tái phát nhiều lần mà không có bất cứ yếu
tố nào khác được nhận diện.
Candida glabrata đề kháng với tất cả các -imidazoles. Khi
đó có thể dùng liệu pháp viên bao boric acid hoặc tím
gentian (gentian violet).
Tác dụng của điều trị Probiotics không được chứng minh.
Dù rằng sự mất tương quan giữa “khuẩn hệ” và “nấm hệ”
bị nghi ngờ là yếu tố thúc đẩy sự phát triển của VVC,
nhưng không có bằng chứng rằng điều trị với probiotics
(L. acidophilus, L. rhamnosus và L. fermentum) sẽ ngăn
ngừa được VVC tái phát. Các điều trị với probiotics chỉ
được dùng theo kinh nghiệm cho những trường hợp VVC
có biến chứng.

Tài liệu bàn về quản lý xuất huyết tử cung bất thường ở tuổi dậy thì, nhấn mạnh sự không ổn định của trục hạ đồi-yên-buồng trứng trong giai đoạn này. Xuất huyết tử cung cơ năng là hiện tượng phổ biến trong độ tuổi dậy thì do rối loạn chức năng phóng noãn và thiếu hụt hormone. Việc điều trị chủ yếu là bảo vệ hệ sinh sản và theo dõi chu kỳ, với liệu pháp nội tiết nếu cần thiết để hỗ trợ sự phát triển nội mạc tử cung.

![Nguyên tắc tiếp cận và quản lý một khối ở phần phụ
Các nguyên lý của điều trị khối u buồng trứng
2
Đối với các cấu trúc có khả năng lành tính cao: thuộc dân
số nguy cơ thấp, thỏa các qui tắc lành tính IOTA, ROMA
thấp… thì có thể chỉ định phẫu thuật nội soi bảo tồn.
Qua nội soi, một lần nữa đánh giá lại khả năng lành-ác của
u qua đại thể quan sát được trước khi thực hiện bóc u bảo
tồn mô lành ở người trẻ. Phẫu thuật phải ở mức sang chấn
thấp nhất có thể, nhằm tránh ảnh hưởng xấu đến dự trữ
buồng trứng. Đối với người lớn tuổi, phẫn thuật cắt phần
phụ được khuyến cáo thay vì phẫu thuật bảo tồn.
Đối với các cấu trúc có khả năng lành tính thấp, hay nghi
ngờ ác tính, mang các đặc tính của các qui tắc ác tính
IOTA, ROMA cao… thì phải được đánh giá qua mở bụng.
Khi đã vào ổ bụng, việc thám sát một cách cẩn trọng tình
trạng ở bụng là một đòi hỏi tiên quyết.
1. Tế bào học dịch báng, dịch ổ bụng phải được thực
hiện trước tiên, nhằm đánh giá sự lan truyền trong
phúc mạc của ung thư.
2. Thám sát tất cả các cơ quan có thể có liên quan gồm
dạ dày, các tạng bụng, kể cả ruột thừa nhằm giúp đánh
giá các cơ quan có liên hệ mật thiết về mặt ung thư
học (di căn Krukenberg, kèm theo các ung thư khác
như ung thư đại trực tràng…).
3. Khi đã xác định ung thư, với khối u, thực hiện phẫu
thuật ở mức tối đa nhưng hợp lý, cắt bỏ khối ung thư
trên buồng trứng và những vị trí u xâm lấn hay di căn
nếu có thể. Mục đích của phẫu thuật là để loại bỏ càng
nhiều khối u càng tốt. Phải cắt trọn u, không được làm
vỡ u. Cắt ruột thừa, cắt mạc nối lớn là cần thiết.
4. Sau khi phẫu thuật, cần cung cấp đủ thông tin TNM
cho xác định giai đoạn của ung thư (FIGO).
5. Điều trị bổ sung sau phẫu thuật sẽ được xác định bởi
loại ung thư, giai đoạn của bệnh, và grade mô bệnh
học. Điều trị bổ túc có thể là xạ trị hay hóa trị phối
hợp (carboplatin, cisplatin, palitaxel…) tùy theo giải
phẫu bệnh và giai đoạn ung thư. Tuy nhiên, chủ yếu
vẫn là hóa trị
6. Nội soi lần thứ nhì để đánh giá (second look) nhằm
đánh giá hiệu quả điều trị và tái phát của u.
PHÒNG NGỪA UNG THƯ BUỒNG TRỨNG
Mang thai kỳ đủ tháng, cho con bú và sử dụng COCs làm
giảm đáng kể nguy cơ ung thư thượng mô buồng trứng.
Các hành động này có tác dụng bảo vệ khỏi ung thư buồng
trứng do làm giảm số chu kỳ có phóng noãn trong suốt
cuộc đời.
Cắt buồng trứng dự phòng là biện pháp duy nhất có thể
ngăn ngừa ung thư buồng trứng.
Có hai tình huống bàn cãi về cắt buồng trứng dự phòng.
Đối với những người có nguy cơ cực cao mắc ung thư
buồng trứng do di truyền liên quan đến đột biến gene
BRCA, việc cắt buồng trứng dự phòng có thể được chấp
nhận. Cắt buồng trứng dự phòng có thể được thực hiện
trong một cuộc mổ riêng hay trong một cuộc mổ cắt tử
cung vì một lý do nào khác.
Đối với những người không có nguy cơ cao của ung thư
buồng trứng, tranh cãi nằm ở vấn đề là cắt buồng trứng
hay chừa buồng trứng khi thực hiện một phẫu thuật cắt tử
cung vì một lý do khác.
Ở những phụ nữ không có nguy cơ cao ung thư buồng
trứng và hiện phải cắt tử cung vì lý do khác với u buồng
trứng, Hiệp Hội Sản Phụ Khoa Hoa Kỳ (ACOG) viết:
“Khuyến cáo để lại buồng trứng nếu như người phụ nữ đó
chưa mãn kinh. [Tuy nhiên], xem xét nguy cơ có thể xảy ra
ung thư buồng trứng ở tuổi mãn kinh, việc cắt bỏ buồng
trứng có thể được xem xét”. Đến nay, tranh luận vẫn chưa
có câu trả lời.
Hình 1: Các giai đoạn của ung thư buồng trứng theo FIGO
Giai đoạn I: giới hạn ở buồng trứng
Ia: 1 buồng trứng
Ib: 2 buồng trứng
Ic: 1 hoặc 2 buồng trứng, vỏ bọc vỡ hoặc dịch ổ bụng hoặc dịch rửa
ổ bụng có chứa TB ác tính
Giai đoạn II: ung thư 1 hay 2 buồng trứng có di căn vùng chậu
IIa: di căn tử cung và/hoặc vòi trứng
IIb: di căn các nơi khác trong vùng chậu
IIc: IIa hoặc IIb, vỏ bọc vỡ, dịch ổ bụng hoặc dịch rửa ổ bụng có tế
bào ác tính
Giai đoạn III: ung thư 1 hay 2 buồng trứng lan ra ngoài vùng chậu
và/hoặc có hạch sau phúc mạc, hạch bẹn, di căn bề mặt gan, di căn vi
thể mạc nối lớn, mạc treo ruột non
IIIa: không di căn hạch nhưng có di căn phúc mạc vi thể
IIIb: có di căn phúc mạc bụng đại thể > 2cm, không di căn hạch
IIIc: IIIb và/hoặc có di căn hạch sau phúc mạc hay hạch bẹn
Giai đoạn IV: di căn xa, tràn dịch màng phổi, di căn nhu mô gan.
Nguồn: nethealthbook.com
TÀI LIỆU ĐỌC THÊM
1. Obstetrics and gynecology 7th
edition. Tác giả Beckmann. Hợp tác xuất bản với ACOG. Nhà xuất bản Wolters Kluwer Health 2014.
TÀI LIỆU THAM KHẢO CHÍNH
1. NICE (National Instititute for Health and care Excellence) . Ovarian cancer: the recognition and initial management of ovarian cancer (CG122). 2011](https://image.slidesharecdn.com/snschtblphkhoa2020-211007013745/85/S-n-sach-tbl-ph-khoa-2020-119-320.jpg)




































![Thực hành tránh thai
Các đặc tính của một phương pháp tránh thai. Tư vấn lựa chọn một phương pháp tránh thai
1
Các đặc tính của một phương pháp tránh thai
Tư vấn lựa chọn một phương pháp tránh thai
Âu Nhựt Luân
Mục tiêu bài giảng
Sau khi học xong, sinh viên có khả năng:
1. Phân tích được tính hiệu quả của một phương pháp tránh thai
2. Phân tích được tính an toàn của một phương pháp tránh thai
3. Phân tích được khía cạnh kinh tế của một phương pháp tránh thai
4. Phân tích được tính phù hợp của một phương pháp tránh thai cụ thể với hoàn cảnh cá nhân, gia đình và xã hội
5. Mô tả được các giai đoạn của tiến trình tư vấn lựa chọn một phương pháp tránh thai
Tránh thai được định nghĩa là hành động có chủ ý dùng
các biện pháp nhân tạo hay các kỹ thuật để ngăn ngừa
mang thai hậu quả của giao hợp.
Có nhiều phương pháp tránh thai, hoạt động dựa trên
những nguyên lý và cơ chế khác nhau.
Mỗi phương pháp được đặc trưng bằng:
1. Tính hiệu quả
2. Tính an toàn
3. Tính kinh tế
4. Khả năng chấp nhận của người dùng cụ thể
Hiệu quả của một phương pháp tránh thai được tính bằng
chỉ số Pearl.
Chỉ số Pearl được định nghĩa là số thai kỳ quan sát thấy
trên 100 năm phụ nữ 1
.
Năm 1933, Raymond Pearl đề nghị một phương pháp để
mô tả tính hiệu quả của một phương pháp tránh thai: Chỉ
số Pearl (Pearl Index) (PI).
Dù đã hơn 80 năm qua, nhưng chỉ số Pearl PI hiện vẫn
được dùng rộng rãi do rất đơn giản.
Đơn vị của PI là số thai kỳ thấy được trong 100 năm phụ
nữ (Hundred Woman Years) (HWY).
Có hai cách tính Chỉ số Pearl:
Chỉ số Pearl = [ Số thai kỳ quan sát thấy: Tổng số chu
kỳ thực tế đã quan sát ] x 1200
Chỉ số Pearl = [ Số thai kỳ quan sát thấy: Tổng số chu
kỳ thực tế đã quan sát ] x 1300
PI thể hiện tính hiệu quả của một phương pháp tránh thai
trong trường hợp sử dụng hoàn hảo.
Trong trường hợp sử dụng không hoàn hảo, thường thì
người ta không dùng PI.
Đôi khi, người ta dùng PI để so sánh hiệu quả của 2
phương pháp tránh thai khác nhau với nhau.
Tính hiệu quả của phương pháp lệ thuộc vào bản thân của
phương pháp, đồng thời cũng bị thay đổi theo tình trạng
thể chất của người dùng cụ thể.
1
Lưu ý: 100 năm, mỗi năm có 13 chu kỳ 28 ngày
Hình 1: Hiệu quả của các phương pháp tránh thai
Tính hiệu quả của một phương pháp tránh thai được thể hiện qua chỉ số
Pearl. Các phương pháp tránh thai có chỉ số Pearl thấp nhất là các
phương pháp có hiệu quả cao nhất.
Trong số các phương pháp tránh thai tạm thời, que cấy phóng thích
chậm progestogen, dụng cụ tử cung phóng thích chậm progestogen và
dụng cụ tử cung chứa đồng là các phương pháp hiệu quả nhất.
Thuốc tiêm phóng thích chậm progestogen, viên estrogen-progestogen
phối hợp, vòng đặt âm đạo phóng thích chậm estrogen-progestogen
cũng có hiệu quả tránh thai khá cao.
Nguồn: wikipedia.org
Tính an toàn của một phương pháp tránh thai được WHO
xếp theo các mức độ giới hạn việc dùng, từ loại 1 đến 4.
Mỗi phương pháp tránh thai đều có thể có tác động ngoài
tránh thai. Phương pháp có thể làm thay đổi tình trạng sức
khỏe của người dùng theo chiều hướng xấu đi hoặc có thể
gây hại cho người dùng. Vì thế, khi quyết định dùng một
phương pháp tránh thai, phải cân nhắc giữa hiệu quả tránh
thai và những bất lợi mà phương pháp này có thể gây ra
cho người dùng cụ thể.
Hầu hết các hướng dẫn tránh thai hiện đại đều không còn
dùng các từ “chỉ định” và “chống chỉ định” khi nói về các
phương pháp tránh thai.
Một cách hiển nhiên, “chỉ định” dùng một phương pháp
tránh thai là để tránh thai. Nói đến “chỉ định” là không cần
thiết.](https://image.slidesharecdn.com/snschtblphkhoa2020-211007013745/85/S-n-sach-tbl-ph-khoa-2020-156-320.jpg)


































![Phá thai an toàn
Phá thai an toàn: khái niệm cơ bản về cung cấp dịch vụ phá thai an toàn
1
Phá thai an toàn: khái niệm cơ bản về cung cấp dịch vụ phá thai an toàn
Lê Hồng Cẩm
Mục tiêu bài giảng
Sau khi học xong, sinh viên có khả năng:
1. Trình bày được định nghĩa phá thai không an toàn, các biến chứng có thể gặp
2. Trình bày được định nghĩa phá thai an toàn
3. Trình bày được các bước của của dịch vụ phá thai an toàn
Phá thai là một hành vi phổ biến trên toàn cầu.
Mặc dù số phá thai trên toàn cầu giảm từ 46 triệu (năm
1995) còn 42 triệu (năm 2003), nhưng phần lớn chỉ giảm ở
những nước đã phát triển. Trong khi đó, hơn 50% phá thai
không hợp pháp và không an toàn xảy ra ở những nước
đang phát triển.
Những nơi phá thai thai hợp pháp thường là an toàn. Nếu
phá thai không hợp pháp thì biến chứng rất thường gặp.
Hàng năm trên thế giới khoảng 47.000 phụ nữ tử vong vì
những biến chứng của phá thai không an toàn [WHO
2015]. Trong một nghiên cứu về tỷ lệ tử vong liên quan
đến thai kỳ và phá thai, sử dụng các dữ liệu từ năm 1998-
2005, tỷ lệ tử vong liên quan đến phá thai là 0.6 trên
100.000 trường hợp phá thai so với 8-10 phụ nữ tử vong
liên quan đến thai kỳ trong 100.000 trường hợp sinh sống
(cao hơn 14 lần), điều này có nghĩa là phá thai an toàn hơn
là tiếp tục thai kỳ [Grimes 2012]. Tỷ lệ tử vong do phá thai
nội khoa là 0,7/100.000 người.
Phá thai không an toàn gây ra nhiều ảnh hưởng xấu lên sức
khoẻ và khả năng sinh sản của người phụ nữ.
Tổ chức Y tế Thế giới định nghĩa “phá thai không an toàn”
là quá trình chấm dứt một thai kỳ ngoài ý muốn được thực
hiện bởi những người thiếu những kỹ năng cần thiết hay là
thực hiện trong môi trường không đáp ứng được các tiêu
chuẩn y tế tối thiểu hoặc cả hai.
Kết cục của phá thai không an toàn phụ thuộc vào kỹ năng
của người thực hiện, cách thức phá thai, sức khoẻ của
người phụ nữ, và tuổi thai.
Các biến chứng của phá thai không an toàn gồm: chảy máu
nhiều, chấn thương âm đạo, cổ tử cung, tử cung, các cơ
quan trong ổ bụng, nhiễm trùng, viêm phúc mạc, và hiếm
muộn về sau.
Phá thai an toàn là phá thai ở các quốc gia cho phép phá
thai vì lý do xã hội hay kinh tế, được luật pháp bảo vệ.
Phá thai an toàn giúp giảm thiểu tỉ lệ gặp các tai biến so
với phá thai không an toàn. Từ đó giúp bảo vệ sức khoẻ
cho người phụ nữ và giảm chi phí y tế cho xã hội do giảm
chi phí điều trị các biến chứng của phá thai không an toàn.
Nguy cơ tử vong do phá thai an toàn giảm đáng kể từ
4:100000 (năm 1972) xuống 1:100000 (năm 1987). Nguy
cơ chết do hút thai dưới 8 tuần từ 0:100000 tăng lên
0.2:100000 nếu tuổi thai 9-10 tuần, đến 7.2:100000 nếu
tuổi thai từ 21 tuần trở lên. Khoảng 87% tử vong do phá
thai to có thể tránh được nếu thai phụ chấm dứt thai kỳ
trước 8 tuần. Như vậy nguy cơ sẽ tăng nếu tuổi thai càng
lớn.
Tại các quốc gia mà việc phá thai là hợp pháp, thì nhà
nước có trách nhiệm đảm bảo cung cấp dịch vụ phá thai an
toàn.
Cung cấp dịch vụ phá thai an toàn bao gồm:
1. Khám và tư vấn trước phá thai
2. Lựa chọn phương pháp phá thai
3. Theo dõi và chăm sóc sau phá thai
Khám và tư vấn trước phá thai là điều kiện tiên quyết của
phá thai an toàn.
Khám trước phá thai cung cấp một cái nhìn tổng thể, giúp
quyết định kế hoạch thực hiện phá thai an toàn phù hợp
cho mỗi cá nhân khách hàng.
Nội dung của khám trước phá thai gồm:
1. Xác định tuổi thai
2. Loại trừ các thai kỳ bất thường như thai ngoài tử cung,
thai ở sẹo mổ sanh cũ, thai trứng
3. Loại trừ các trường hợp chống chỉ định của một hay
nhiều phương pháp như nhiễm trùng sinh dục, các
khối u tử cung, các tình trạng nội khoa
Trước phá thai, xác định tuổi thai là yếu tố rất quan trọng
để chọn cách chấm dứt thai kỳ. Dựa trên bệnh sử, khám
bụng, âm đạo, xét nghiệm và siêu âm nếu cần.
Nội dung của tư vấn trước phá thai gồm:
1. Thông tin về tiến trình phá thai
2. Biến chứng và cách heo dõi biến chứng
3. Tránh thai sau phá thai
Cần có tờ thông tin hướng dẫn đầy đủ, dễ hiểu về cách tiến
hành phá thai, các biến chứng và theo dõi sau phá thai để
khách hàng có thể hiểu và tự theo dõi. Tư vấn ngừa thai
sau phá thai cũng rất quan trọng.
Đối với phá thai ngoại khoa, cần cho kháng sinh dự phòng
trước hay ngay khi làm thủ thuật.
Lựa chọn phương pháp phá thai thích hợp với tình trạng
thai kỳ và với cá nhân người khách hàng.
Biện pháp phá thai thích hợp được hiểu là thích hợp theo:
1. Tình trạng thai.
Tuổi thai là yếu tố có ảnh hưởng quyết định.
2. Tình trạng sức khỏe, bệnh tật của người khách hàng.
Chống chỉ định của phá thai nội khoa, tình trạng viêm
âm đạo… sẽ ảnh hưởng đến quyết định lựa chọn
phương pháp.
3. Điều kiện thực hành phá thai.](https://image.slidesharecdn.com/snschtblphkhoa2020-211007013745/85/S-n-sach-tbl-ph-khoa-2020-191-320.jpg)

![Phá thai an toàn
Phá thai nội khoa: chất điều hoà chọn lọc thụ thể progesterone và misoprostol. Hiệu quả, biến chứng và giới hạn của chỉ định
1
Phá thai nội khoa:
Chất điều hoà chọn lọc thụ thể progesterone và misoprostol
Hiệu quả, biến chứng và giới hạn của chỉ định
Lê Hồng Cẩm
Mục tiêu bài giảng
Sau khi học xong, sinh viên có khả năng:
1. Trình bày được tác dụng của mifepristone và misoprostol trong phá thai nội khoa
2. Trình bày được cách dùng mifepristone và misoprostol trong phá thai nội khoa cho thai dưới 12 tuần
3. Trình bày được hiệu quả và chống chỉ định của phá thai nội khoa
4. Trình bày được tác dụng phụ và biến chứng của phá thai nội khoa
Mifepristone là một Selective Progesterone Receptor
Modulator.
Mifepristone là một chất dẫn xuất của norethindrone.
Vòng A của phân tử mifepristone có một chức ketone và
một nối đôi ở vị trí C4 giúp mifepristone gắn kết vào thụ
thể của progesterone, với ái lực cao hơn của progesterone
rất nhiều. Điều này cho phép mifepristone cạnh tranh với
progesterone trên thụ thể của progesterone, chiếm chỗ của
progesterone và ngăn không cho progesterone gắn vào thụ
thể của nó.
Hình 1: Phân tử mifepristone
Cấu trúc vòng A với chức ketone và nối đôi ở C4, tạo ái lực mạnh với
receptor của progesterone, cạnh tranh mạnh với progesterone.
Nguồn: Bộ môn Phụ Sản, Đại học Y Dược TP HCM
Khi gắn vào thụ thể của progesterone, hoạt tính chủ yếu
của mifepristone là kháng progesterone.
Hình 2: Gắn kết bình thường của progesterone lên thụ thể
Mifepristone không gắn được với co-activator, nên không điều hoà được
gene, gây hoạt tính kháng progesterone.
Nguồn: researchgate.ne
Tuy gắn được với thụ thể của progesterone nhưng do cấu
trúc phần còn lại của phân tử mifepristone đã ngăn cản
phức bộ [Progesterone-Thụ thể-Heat shock protein 90] gắn
với co-activator, vì thế không điều hoà được các gene
tương ứng của progesterone. Các gene này không được
điều hoà lên, gây hệ quả là một hoạt tính kháng
progesterone.
Do gắn kết cạnh tranh và bất hoạt thụ thể nên mifepristone
là chất ngăn chặn hoạt động của progesterone.
Trên hạ đồi, do tác động non-genomic, mifepristone có
hoạt tính progestogenic, gây ức chế nhịp điệu của xung
GnRH và gây sụt giảm LH. Hệ quả là ly giải hoàng thể.
Như vậy, không chỉ cạnh tranh với progesterone tự nhiên,
mifepristone còn gây tiêu huỷ nguồn progesterone tự nhiên
duy nhất của cơ thể là hoàng thể, nếu như nó đang tồn tại.
Kết hợp mifepristone và misoprostol tạo được kết cục gây
sẩy thai thành công cao trên cả thai sống và thai lưu.
Về mặt thực hành, trên tử cung có thai, hoạt tính kháng
progesterone của mifepristone làm hoại tử lớp màng rụng.
Vắng mặt hoạt tính progestogenic gây tăng tương đối hoạt
tính estrogenic, với hệ quả là co thắt cơ tử cung, tăng nhạy
cảm với prostaglandin và mềm cổ tử cung.
Do các tác dụng trên, mifepristone có thể gây sẩy thai mà
không cần phối hợp với bất cứ hoạt chất nào khác. Tuy
nhiên, khả năng gây sẩy thai thành công và hoàn toàn của
mifepristone không cao. Nghiên cứu trên người cho thấy,
việc dùng thêm misoprostol theo sau mifepristone làm
tăng hiệu quả gây sẩy thai của mifepristone lên nhiều lần.
Ngược lại, việc chuẩn bị trước với mifepristone cũng làm
tăng hiệu quả gây sẩy thai của misoprostol so với dùng
misoprostol đơn độc trong các trường hợp thai lưu.
Misoprostol là chất tương tự prostaglndine E1, có tác dụng
gây co thắt tử cung, tống xuất các sản phẩm thụ thai.
Cấu trúc gần giống hệt prostaglandin E1 của misoprostol
làm tử cung co thắt làm tống xuất thai và các sản phẩm thụ
thai ra khỏi tử cung.
Là thuốc nguyên thuỷ có tác dụng bảo vệ niêm mạc dạ dày
ở những người dùng NSAID. Sau này, misoprostol đã
được FDA chấp nhận cho sử dụng trong phá thai nội khoa.
Trên thai sống, trong môi trường giàu progesterone,
misoprostol không thể gây sẩy thai một cách hiệu quả.
Trên thai chết, khi lượng progesterone từ nhau và hoàng](https://image.slidesharecdn.com/snschtblphkhoa2020-211007013745/85/S-n-sach-tbl-ph-khoa-2020-193-320.jpg)




![Phá thai an toàn
Phá thai ngoại khoa: hiệu quả, biến chứng và giới hạn của chỉ định
3
TIẾN TRÌNH PHÁ THAI NGOẠI KHOA
Sau khi tư vấn khách hàng và khách hàng ký giấy cam kết
đồng thuận, loại thủ thuật được thực hiện tùy theo tuổi thai
và mong muốn của bệnh nhân.
Thăm khám bằng tay cẩn thận để xác định kích thước và
tư thế của tử cung.
Trong tam ca nguyệt thứ hai, nong cổ tử cung bằng dụng
cụ nong áp lực thẩm thấu (luminaria hoặc dilapan) hoặc
một prostaglandin analogue (misoprostol) có hoặc không
có nong áp lực thẩm thấu kèm theo 2
. Chuẩn bị cổ tử cung
bằng Dilapan hay Misoprostol làm giảm tỉ lệ tai biến và
giúp rút ngắn thời gian thực hiện thủ thuật ở những thai kỳ
có tuổi thai lớn. Việc nong cổ tử cung cùng ngày thực hiện
thủ thuật giúp thuận tiện cho khách hàng.
Kháng sinh quanh thời điểm thủ thuật giúp giảm nguy cơ
nhiễm trùng sau thủ thuật. Tuy nhiên, chưa có nghiên cứu
nào chứng minh phác đồ đơn liều hiệu quả hơn phác đồ
khác.
Nghiên cứu tốt nhất ủng hộ việc sử dụng Doxycycline
1g Azithromycin có thể được sử dụng
Nếu có nhiễm chlamydia, sử dụng Doxycycline trong
7 ngày hay Azithromycin 1g liều duy nhất.
Nếu có viêm đạo do vi khuẩn (bacterial vaginosis),
điều trị kháng sinh thích hợp 3
Lau cổ ngoài cổ tử cung, và cổ trong cổ tử cung
Gây tê cổ tử cung, có thể sử dụng thuốc an thần nếu muốn.
Kẹp cổ tử cung bằng kềm pozzi và nong cổ tử cung cơ học
nếu cổ tử cung chưa được nong đủ.
Sử dụng kỹ thuật vô trùng, đặt một ống bằng nhựa và hút
thai hoặc bằng máy hay hút hoặc bằng tay hoặc bằng dụng
cụ hút chân không bằng tay (MVA)
Đánh giá mô để xác định sự hiện diện của túi thai, gai
nhau nếu thai nhỏ. Nếu thai trên 9 tuần, phải thấy được mô
thai. Nếu không thấy gai nhau, cần lưu ý đi tìm khả năng
thai ngoài tử cung.
Tiêm Globulin miễn dịch Rhesus nếu khách hàng có nhóm
máu Rhesus âm.
CÁC BIẾN CHỨNG CỦA PHÁ THAI NGOẠI KHOA
So với phá thai nội khoa, phá thai ngoại khoa ít có nguy cơ
sót sản phẩm thụ thai hơn. NNT = 8.
Tuy nhiên, nguy cơ xảy ra biến chứng thủng, nhiễm trùng
là cao hơn phá thai nội khoa.
Khi thực hiện phá thai nội khoa, việc sót sản phẩm thụ thai
lệ thuộc vào khả năng tống xuất bằng cơn co tử cung. Sót
sản phẩm thụ thai thường gặp ở phá thai nội khoa hơn là
phá thai ngoại khoa. Tuy nhiên, điều này không làm giảm
giá trị của phá thai nội khoa, do phá thai nội khoa phải đối
mặt với các nhuy cơ quan trọng là nhiễm trùng và thủng tử
cung khi thực hiện thủ thuật.
2
Hai nghiên cứu gần đây [Lyons 2013], [Maurer 2013] cho thấy việc
chuẩn bị cổ tử cung bằng Dilapan hay Misoprostol có liên quan đến giảm
tỉ lệ tai biến và giúp rút ngắn thời gian thực hiện thủ thuật ở những thai
kỳ có tuổi thai đến 21 tuần 6 ngày.
3
[Reeves M. et al. 2011]
Nhiễm trùng là biến chứng muộn của phá thai ngoại khoa,
có thể kèm theo sót sản phẩm thụ thai.
Triệu chứng lâm sàng của nhiễm trùng sau phá thai ngoại
khoa cũng giống như các trường hợp viêm nội mạc tử cung
và thêm vào đó là có sót sản phẩm thụ thai trong lòng tử
cung (mô nhau, mô thai, màng thai). Các triệu chứng gồm
sốt, tử cung lớn và mềm, đau bụng dưới và ra máu âm đạo
nhiều hơn mong đợi. Siêu âm sẽ giúp xác định có sót mô
hay không. Việc điều trị phải tuân thủ nguyên tắc là lấy hết
mô còn sót, kết hợp với kháng sinh phổ rộng, bao phủ cả
vi khuẩn yếm khí.
Tần suất của nhiễm trùng nội mạc tử cung sau phá thai
ngoại khoa vào khoảng 5-20% khi không sử dụng kháng
sinh. Kháng sinh dự phòng làm giảm đi ½ số ca bị viêm
nội mạc tử cung. Các kháng sinh thường dùng là:
doxycycline 100 mg uống 2 lần mỗi ngày (lúc no), hay
ofloxacin 400 mg uống 2 lần mỗi ngày, trong ngày làm thủ
thuật, hoặc ceftriaxone 1 g truyền tĩnh mạch 30 phút trước
thủ thuật.
Thủng tử cung là biến chứng sớm của phá thai ngoại khoa,
có thể xảy ra cho mọi phá thai ở bất cứ tuổi thai nào.
Thủng tử cung có thể xảy ra cho mọi phá thai ở bất cứ tuổi
thai nào, với tỉ lệ chung là 0.6%. Tuy nhiên, thủng tử cung
thường xảy ra hơn với các thai to hơn là thai nhỏ, với ống
hút cứng hơn là ống hút mềm, với thủ thuật có nong cổ tử
cung bằng dụng cụ hơn là thủ thuật không có nong cổ tử
cung bằng dụng cụ.
Có thể hạn chế biến chứng này khi người làm thủ thuật có
nhiều kinh nghiệm và nong cổ tử cung bằng các chất hút
nước khi phải thực hiện phá thai to trên 12 tuần.
Hình 4: Thủng tử cung do que nong Hegar (trái) và do thìa nạo (phải)
Thủng thường xảy ra ở đoạn eo tử cung.
Hình 4a: Thủng tử cung thường xảy ra nhất ở thì nong, khi que nong
cứng vượt qua một trở kháng lớn là cổ tử cung chật và cứng.
Hình 4b: Thủng cũng có thể xảy ra ở thì nạo bằng thìa.
Vì thế, ngày nay, trong phá thai an toàn, người ta rất hạn chế dùng thìa
kim loại để nạo buồng tử cung.
Nguồn: glowm.com
Chảy máu nhiều là triệu chứng của một biến chứng sớm và
nặng. Cần phải tìm nguyên nhân để có xử trí thích hợp.
Chảy máu nhiều sau thủ thuật phá thai có thể do rách cổ tử
cung, âm đạo, thủng tử cung, sót mô hay đờ tử cung.
Một số nguyên nhân khác hiếm gặp hơn như phân bố động
tĩnh mạch ở tử cung bất thường, nhau cài răng lược hay](https://image.slidesharecdn.com/snschtblphkhoa2020-211007013745/85/S-n-sach-tbl-ph-khoa-2020-198-320.jpg)









![Nguyên tắc tiếp cận và quản lý các vấn đề về tuyến vú
Chiến lược tầm soát ung thư vú
5
Với phụ nữ ≥ 45 tuổi và có nguy cơ bình quân, nhũ
ảnh thường qui được chỉ định hàng năm.
Sau 55 tuổi, nhũ ảnh có thể được tiếp tục với mật độ
thưa hơn, mỗi 2 năm một lần.
Âm tính giả (FNR) của nhũ ảnh với tầm soát ung thư vú là
25-30% ở phụ nữ 40-49 tuổi, và là 10% ở phụ nữ trên 49
tuổi.
Khi thực hiện nhũ ảnh thường qui tầm soát ung thư vú ở
mọi phụ nữ trong độ tuổi 40-49 tuổi, sẽ có ít nhất một lần
dương tính giả.
Nhũ ảnh thường qui đơn thuần không được chỉ định ở
những đối tượng có nguy cơ cao theo mô hình Claus, và
các đối tượng có nguy cơ cao đặc biệt khác.
Dù rằng MRI có độ nhạy rất cao, nhưng vẫn có khả năng
bỏ sót tổn thương.
MRI phải được thực hiện kèm theo chứ không phải là thay
cho nhũ ảnh ở các đối tượng có nguy cơ cao ung thư vú.
Đối với các đối tượng nguy cao đặc biệt của ung thư vú,
không thực hiện tầm soát bằng nhũ ảnh đơn thuần .
Ở các đối tượng này, việc tầm soát phải được thực hiện
bằng cộng hưởng từ (MRI) và nhũ ảnh hàng năm.
Các tổ chức/hiệp hội khác nhau đưa ra các quan điểm khác
nhau về chiến lược tầm soát, như trình bày trong bảng 2.
Bảng 2: Lịch tầm soát ung thư vú bằng các phương tiện khác nhau cho
phụ nữ với nguy cơ cao, theo các tổ chức/hiệp hội khác nhau tại Hoa Kỳ
Các phụ nữ sau được xếp vào nhóm có nguy cơ cao của
ung thư vú và cần được thực hiện tầm soát hàng năm bằng
MRI phối hợp với nhũ ảnh:
Có lifetime risk theo tiền sử bị ung thư vú 20-25%
hoặc cao hơn
Có đột biến gene BRCA
Chưa được khảo sát đột biến BRCA nhưng có người
thân trực hệ (cha mẹ, anh, chị, em hay con) có mang
đột biến gene BRCA1 hay BRCA2
Từng bị chiếu xạ vùng ngực trong độ tuổi 10-30 tuổi
Mắc hội chứng Li-Fraumeni 4
, hội chứng Cowden 5
,
hay hội chứng Bannayan-Riley-Ruvalcaba 6
, hay có
người thân trực hệ có một trong các hội chứng này
Do chưa đủ bằng chứng cho dân số có nguy cơ cao ung
thư vú, nên ACS đề nghị thực hiện tầm soát phối hợp trên
kể từ năm 30 tuổi, với sự đồng thuận của bệnh nhân, cho
hầu hết các trường hợp nguy cơ cao.
Phụ nữ có tiền căn chiếu xạ ngực lúc 10-30 tuổi cần được
thực hiện tầm soát kép nhũ ảnh-MRI hàng năm, bắt đầu từ
8-10 năm kể từ khi bị chiếu xạ hoặc bắt đầu lúc 25 tuổi
Không đủ bằng chứng về hiệu quả của việc thực hiện đơn
thuần MRI hàng năm ở phụ nữ có tiền căn ung thư vú
(cùng hay đối bên), sinh thiết vú với kết quả nguy cơ cao
như tăng sinh ống không điển hình (atypical ductal
hyperplasia) (ADH), carcinom tại chỗ tiểu thùy (lobular
carcinoma in situ) (LCIS), carcinom ống tại chỗ (ductal
carcinoma in situ) (DCIS).
Các bệnh nhân có nguy cơ đặc biệt cao này phải được theo
dõi bằng phối hợp nhũ ảnh-MRI, có hay không kèm theo
các biện pháp hỗ trợ khác.
4
Hội chứng Li–Fraumeni là một ung thư hiếm, di truyền theo kiểu gen
trội trên nhiễm sắc thể thường. Đặc trưng bởi sarcoma, vú, bệnh bạch cầu
và tuyến thượng thận.
Bệnh liên quan đến đột biến của gene p53 ức chế khối u.
5
Hội chứng Cowden hay còn gọi là hội chứng đa hamartoma là một bệnh
hiếm, đặc trưng bởi các tình trạng giống khối u không ung thư gọi là
hamartoma.
Là một bệnh di truyền theo gene trội trên nhiễm sắc thể thường, liên quan
đến gene PTEN, là một gene ức chế khối u.
6
Tương tự như hội chứng Cowden, hội chứng Bannayan-Riley-
Ruvalcaba cũng là một bệnh di truyền gene trội trên nhiễm sắc thể
thường và cũng có liên quan đến đột biến gene PTEN.
TÀI LIỆU ĐỌC THÊM
1. Obstetrics and gynecology 7th
edition. Tác giả Beckmann. Hợp tác xuất bản với ACOG. Nhà xuất bản Wolters Kluwer Health 2014.
TÀI LIỆU THAM KHẢO CHÍNH
1. Siu AL. Screening for breast cancer: U.S. Preventive Services Task Force recommendation statement. U.S. Preventive Services Task Force [published
erratum appears in Ann Intern Med 2016;164:448]. Ann Intern Med 2016;164:279–96. (Level III)
2. National Comprehensive Cancer Network. Breast cancer screening and diagnosis. Version 1.2016. (Level III)
3. Diagnosis and management of benign breast disorders. Practice Bulletin No. 164. American College of Obstetricians and Gynecologists. Obstet Gynecol
2016;127:e141–56. (Level III)
4. Breast cancer risk assessment and screening in average risk women. Practice Bulletin No. 179. American College of Obstetricians and Gynecologists.
Obstet Gynecol 2017;130(1):e1-e16.
5. Oeffinger KC, Fontham ET, Etzioni R, Herzig A, Michaelson JS, Shih YC, et al. Breast cancer screening for women at average risk: 2015 guideline
update from the American Cancer Society [published erratum appears in JAMA 2016;315:1406]. JAMA 2015;314:1599–614. (Level III)
6. Nelson HD, Cantor A, Humphrey L, Fu R, Pappas M, Daeges M, et al. Screening for breast cancer: a systematic review to update the 2009 U.S.
Preventive Services Task Force recommendation. Evidence Syntheses, No. 124. Rockville (MD): Agency for Healthcare Research and Quality; 2016.
(Systematic Review)
7. American College of Obstetricians-Gynecologists. Practice bulletin no. 122: Breast cancer screening. Obstetrics and Gynecology 2011;118(2 Pt 1):372–
382.
Cowden](https://image.slidesharecdn.com/snschtblphkhoa2020-211007013745/85/S-n-sach-tbl-ph-khoa-2020-208-320.jpg)

















![[Sản sách] tbl phụ khoa 2020](https://image.slidesharecdn.com/snschtblphkhoa2020-211007013745/85/S-n-sach-tbl-ph-khoa-2020-226-320.jpg)
![[Sản sách] tbl phụ khoa 2020](https://image.slidesharecdn.com/snschtblphkhoa2020-211007013745/85/S-n-sach-tbl-ph-khoa-2020-227-320.jpg)
![[Sản sách] tbl phụ khoa 2020](https://image.slidesharecdn.com/snschtblphkhoa2020-211007013745/85/S-n-sach-tbl-ph-khoa-2020-228-320.jpg)
![[Sản sách] tbl phụ khoa 2020](https://image.slidesharecdn.com/snschtblphkhoa2020-211007013745/85/S-n-sach-tbl-ph-khoa-2020-229-320.jpg)
![[Sản sách] tbl phụ khoa 2020](https://image.slidesharecdn.com/snschtblphkhoa2020-211007013745/85/S-n-sach-tbl-ph-khoa-2020-230-320.jpg)
![[Sản sách] tbl phụ khoa 2020](https://image.slidesharecdn.com/snschtblphkhoa2020-211007013745/85/S-n-sach-tbl-ph-khoa-2020-231-320.jpg)
![[Sản sách] tbl phụ khoa 2020](https://image.slidesharecdn.com/snschtblphkhoa2020-211007013745/85/S-n-sach-tbl-ph-khoa-2020-232-320.jpg)
![[Sản sách] tbl phụ khoa 2020](https://image.slidesharecdn.com/snschtblphkhoa2020-211007013745/85/S-n-sach-tbl-ph-khoa-2020-233-320.jpg)
![[Sản sách] tbl phụ khoa 2020](https://image.slidesharecdn.com/snschtblphkhoa2020-211007013745/85/S-n-sach-tbl-ph-khoa-2020-234-320.jpg)
![[Sản sách] tbl phụ khoa 2020](https://image.slidesharecdn.com/snschtblphkhoa2020-211007013745/85/S-n-sach-tbl-ph-khoa-2020-235-320.jpg)
![[Sản sách] tbl phụ khoa 2020](https://image.slidesharecdn.com/snschtblphkhoa2020-211007013745/85/S-n-sach-tbl-ph-khoa-2020-236-320.jpg)
![[Sản sách] tbl phụ khoa 2020](https://image.slidesharecdn.com/snschtblphkhoa2020-211007013745/85/S-n-sach-tbl-ph-khoa-2020-237-320.jpg)
![[Sản sách] tbl phụ khoa 2020](https://image.slidesharecdn.com/snschtblphkhoa2020-211007013745/85/S-n-sach-tbl-ph-khoa-2020-238-320.jpg)
![[Sản sách] tbl phụ khoa 2020](https://image.slidesharecdn.com/snschtblphkhoa2020-211007013745/85/S-n-sach-tbl-ph-khoa-2020-239-320.jpg)
![[Sản sách] tbl phụ khoa 2020](https://image.slidesharecdn.com/snschtblphkhoa2020-211007013745/85/S-n-sach-tbl-ph-khoa-2020-240-320.jpg)
![[Sản sách] tbl phụ khoa 2020](https://image.slidesharecdn.com/snschtblphkhoa2020-211007013745/85/S-n-sach-tbl-ph-khoa-2020-241-320.jpg)
![[Sản sách] tbl phụ khoa 2020](https://image.slidesharecdn.com/snschtblphkhoa2020-211007013745/85/S-n-sach-tbl-ph-khoa-2020-242-320.jpg)
![[Sản sách] tbl phụ khoa 2020](https://image.slidesharecdn.com/snschtblphkhoa2020-211007013745/85/S-n-sach-tbl-ph-khoa-2020-243-320.jpg)
![[Sản sách] tbl phụ khoa 2020](https://image.slidesharecdn.com/snschtblphkhoa2020-211007013745/85/S-n-sach-tbl-ph-khoa-2020-244-320.jpg)
![[Sản sách] tbl phụ khoa 2020](https://image.slidesharecdn.com/snschtblphkhoa2020-211007013745/85/S-n-sach-tbl-ph-khoa-2020-245-320.jpg)
![[Sản sách] tbl phụ khoa 2020](https://image.slidesharecdn.com/snschtblphkhoa2020-211007013745/85/S-n-sach-tbl-ph-khoa-2020-246-320.jpg)
![[Sản sách] tbl phụ khoa 2020](https://image.slidesharecdn.com/snschtblphkhoa2020-211007013745/85/S-n-sach-tbl-ph-khoa-2020-247-320.jpg)
![[Sản sách] tbl phụ khoa 2020](https://image.slidesharecdn.com/snschtblphkhoa2020-211007013745/85/S-n-sach-tbl-ph-khoa-2020-248-320.jpg)
![[Sản sách] tbl phụ khoa 2020](https://image.slidesharecdn.com/snschtblphkhoa2020-211007013745/85/S-n-sach-tbl-ph-khoa-2020-249-320.jpg)
![[Sản sách] tbl phụ khoa 2020](https://image.slidesharecdn.com/snschtblphkhoa2020-211007013745/85/S-n-sach-tbl-ph-khoa-2020-250-320.jpg)
![[Sản sách] tbl phụ khoa 2020](https://image.slidesharecdn.com/snschtblphkhoa2020-211007013745/85/S-n-sach-tbl-ph-khoa-2020-251-320.jpg)
![[Sản sách] tbl phụ khoa 2020](https://image.slidesharecdn.com/snschtblphkhoa2020-211007013745/85/S-n-sach-tbl-ph-khoa-2020-252-320.jpg)
![[Sản sách] tbl phụ khoa 2020](https://image.slidesharecdn.com/snschtblphkhoa2020-211007013745/85/S-n-sach-tbl-ph-khoa-2020-253-320.jpg)
![[Sản sách] tbl phụ khoa 2020](https://image.slidesharecdn.com/snschtblphkhoa2020-211007013745/85/S-n-sach-tbl-ph-khoa-2020-254-320.jpg)
![[Sản sách] tbl phụ khoa 2020](https://image.slidesharecdn.com/snschtblphkhoa2020-211007013745/85/S-n-sach-tbl-ph-khoa-2020-255-320.jpg)
![[Sản sách] tbl phụ khoa 2020](https://image.slidesharecdn.com/snschtblphkhoa2020-211007013745/85/S-n-sach-tbl-ph-khoa-2020-256-320.jpg)
![[Sản sách] tbl phụ khoa 2020](https://image.slidesharecdn.com/snschtblphkhoa2020-211007013745/85/S-n-sach-tbl-ph-khoa-2020-257-320.jpg)
![[Sản sách] tbl phụ khoa 2020](https://image.slidesharecdn.com/snschtblphkhoa2020-211007013745/85/S-n-sach-tbl-ph-khoa-2020-258-320.jpg)
![[Sản sách] tbl phụ khoa 2020](https://image.slidesharecdn.com/snschtblphkhoa2020-211007013745/85/S-n-sach-tbl-ph-khoa-2020-259-320.jpg)
![[Sản sách] tbl phụ khoa 2020](https://image.slidesharecdn.com/snschtblphkhoa2020-211007013745/85/S-n-sach-tbl-ph-khoa-2020-260-320.jpg)
![[Sản sách] tbl phụ khoa 2020](https://image.slidesharecdn.com/snschtblphkhoa2020-211007013745/85/S-n-sach-tbl-ph-khoa-2020-261-320.jpg)
![[Sản sách] tbl phụ khoa 2020](https://image.slidesharecdn.com/snschtblphkhoa2020-211007013745/85/S-n-sach-tbl-ph-khoa-2020-262-320.jpg)
![[Sản sách] tbl phụ khoa 2020](https://image.slidesharecdn.com/snschtblphkhoa2020-211007013745/85/S-n-sach-tbl-ph-khoa-2020-263-320.jpg)
![[Sản sách] tbl phụ khoa 2020](https://image.slidesharecdn.com/snschtblphkhoa2020-211007013745/85/S-n-sach-tbl-ph-khoa-2020-264-320.jpg)
![[Sản sách] tbl phụ khoa 2020](https://image.slidesharecdn.com/snschtblphkhoa2020-211007013745/85/S-n-sach-tbl-ph-khoa-2020-265-320.jpg)
![[Sản sách] tbl phụ khoa 2020](https://image.slidesharecdn.com/snschtblphkhoa2020-211007013745/85/S-n-sach-tbl-ph-khoa-2020-266-320.jpg)
![[Sản sách] tbl phụ khoa 2020](https://image.slidesharecdn.com/snschtblphkhoa2020-211007013745/85/S-n-sach-tbl-ph-khoa-2020-267-320.jpg)
![[Sản sách] tbl phụ khoa 2020](https://image.slidesharecdn.com/snschtblphkhoa2020-211007013745/85/S-n-sach-tbl-ph-khoa-2020-268-320.jpg)
![[Sản sách] tbl phụ khoa 2020](https://image.slidesharecdn.com/snschtblphkhoa2020-211007013745/85/S-n-sach-tbl-ph-khoa-2020-269-320.jpg)
![[Sản sách] tbl phụ khoa 2020](https://image.slidesharecdn.com/snschtblphkhoa2020-211007013745/85/S-n-sach-tbl-ph-khoa-2020-270-320.jpg)
![[Sản sách] tbl phụ khoa 2020](https://image.slidesharecdn.com/snschtblphkhoa2020-211007013745/85/S-n-sach-tbl-ph-khoa-2020-271-320.jpg)
![[Sản sách] tbl phụ khoa 2020](https://image.slidesharecdn.com/snschtblphkhoa2020-211007013745/85/S-n-sach-tbl-ph-khoa-2020-272-320.jpg)
![[Sản sách] tbl phụ khoa 2020](https://image.slidesharecdn.com/snschtblphkhoa2020-211007013745/85/S-n-sach-tbl-ph-khoa-2020-273-320.jpg)
![[Sản sách] tbl phụ khoa 2020](https://image.slidesharecdn.com/snschtblphkhoa2020-211007013745/85/S-n-sach-tbl-ph-khoa-2020-274-320.jpg)
![[Sản sách] tbl phụ khoa 2020](https://image.slidesharecdn.com/snschtblphkhoa2020-211007013745/85/S-n-sach-tbl-ph-khoa-2020-275-320.jpg)
![[Sản sách] tbl phụ khoa 2020](https://image.slidesharecdn.com/snschtblphkhoa2020-211007013745/85/S-n-sach-tbl-ph-khoa-2020-276-320.jpg)
![[Sản sách] tbl phụ khoa 2020](https://image.slidesharecdn.com/snschtblphkhoa2020-211007013745/85/S-n-sach-tbl-ph-khoa-2020-277-320.jpg)